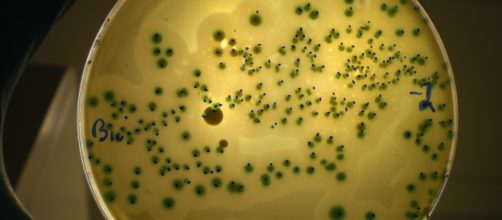
Las 5 bacterias m&aacute;s comunes en los alimentos

Los alimentos por lo general son almacenados en lugares que están expuestos a la presencia de roedores y otros animales e insectos que son portadores de parásitos, luego las personas los adquieren y los llevan a sus casas.
La salmonela
Bacteria asociada a enfermedades gastrointestinales y relacionada con los huevos, algunos afirman que la forma de lavarlos puede incidir en la aparición de esta bacteria dentro del mismo.

Campylobacter
Puede aparecer por no cocinar de manera adecuada la carne del pollo principalmente.

Staphylococcus aereus
Puede estar presente en cremas de pastelería y lácteos por lo que se debe ser exigente en cuanto a la procedencia de los mismos.

Listeria Monocitogenes
Esta bacteria está presente en alimentos procesados que se conservan de manera general bajo refrigeración.

Eschericchia coli
El agua contaminada o aquellos alimentos que se consumen por lo general en forma cruda pueden contener esta bacteria.